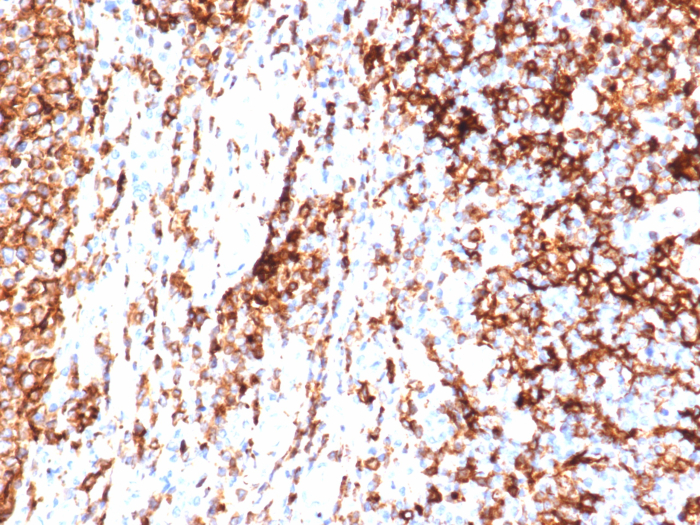
HLA-DR Antibody (HLA-DRA/6840R) - Azide and BSA Free

HLA-DR Antibody (HLA-DRA/6840R) - Azide and BSA Free
Novus Biologicals, part of Bio-Techne | Catalog # NBP3-20837
Recombinant Monoclonal Antibody


Conjugate
Catalog #
Key Product Details
Species Reactivity
Human
Applications
Immunohistochemistry-Paraffin, Immunohistochemistry-Frozen
Label
Unconjugated
Antibody Source
Recombinant Monoclonal Rabbit IgG Kappa Clone # HLA-DRA/6840R
Format
Azide and BSA Free
Concentration
1 mg/ml
Product Specifications
Immunogen
Recombinant fragment (around aa1-200) of human HLA-DR protein (exact sequence is proprietary)
Localization
Cell surface.
Specificity
This monoclonal antibody reacts with the beta-chain of HLA-DR antigen, a member of MHC class II molecules. It does not cross react with HLA-DP and HLA-DQ. The L243 antibody recognizes a different epitope than the HLA-DRA/6840R monoclonal antibody, and these antibodies do not cross-block binding to each others respective epitopes.
Clonality
Monoclonal
Host
Rabbit
Isotype
IgG Kappa
Description
Positive Controls: Human tonsil or lymph node.
Antibody with azide - store at 2 to 8C. Antibody without azide - store at -20 to -80C. Non-hazardous. No MSDS required.
Antibody with azide - store at 2 to 8C. Antibody without azide - store at -20 to -80C. Non-hazardous. No MSDS required.
Scientific Data Images for HLA-DR Antibody (HLA-DRA/6840R) - Azide and BSA Free
HLA-DR Antibody (HLA-DRA/6840R)
Formalin-fixed, paraffin-embedded human tonsil stained with HLA-DR antibody (HLA-DRA/6840R). Inset: PBS instead of primary antibody; secondary only negative control.HLA-DR Antibody (HLA-DRA/6840R)
Formalin-fixed, paraffin-embedded human tonsil stained with HLA-DR antibody (HLA-DRA/6840R). HIER: Tris/EDTA, pH9.0, 45min. Secondary: HRP-polymer, 30min. DAB, 5min.Western Blot: HLA-DR Antibody (HLA-DRA/6840R) - Azide and BSA Free [NBP3-20837] -
Western Blot Analysis of A-375 and tonsil lysates using HLA-DR Antibody (HLA-DRA/6840R) - Azide and BSA Free.Applications for HLA-DR Antibody (HLA-DRA/6840R) - Azide and BSA Free
Application
Recommended Usage
Immunohistochemistry-Frozen
1-2 ug/ml
Immunohistochemistry-Paraffin
1-2 ug/ml
Application Notes
Immunohistochemistry (Frozen & Formalin-fixed): 1-2ug/ml for 30 minutes. at RT. Staining of formalin-fixed tissues is enhanced by boiling tissue sections in 10mM Citrate Buffer, pH 6.0, for 10-20 min followed by cooling at RT for 20 minutes.
Optimal dilution for a specific application should be determined.
Optimal dilution for a specific application should be determined.
Formulation, Preparation, and Storage
Purification
Protein A or G purified
Formulation
10mM PBS
Format
Azide and BSA Free
Preservative
No Preservative
Concentration
1 mg/ml
Shipping
The product is shipped with polar packs. Upon receipt, store it immediately at the temperature recommended below.
Stability & Storage
Store at -20 to -70C. Avoid freeze-thaw cycles.
Background: HLA-DR
Given the role in adaptive immunity, HLA-DR allele polymorphisms, gene misexpression, and dysfunction has been implicated in many diseases ranging from autoimmune disorders to cancer (2). HLA-DR is also a classical biomarker for disease, including sepsis where reduced expression of HLA-DR molecules on monocytes, as measured by flow cytometry, indicates diagnosis and prognosis (4,5). Immunosuppression observed with sepsis results in decreased surface expression of HLA-DR and concurrent increase in expression of programmed death 1 (PD-1), cytotoxic T-lymphocyte antigen 4 (CTLA-4), and B and T lymphocyte attenuator (BTLA) (4). This altered expression results in poor T cell response and apoptosis, along with reduced interferon-gamma (IFN-gamma) production and increased pro-inflammatory cytokine release (4). Furthermore, the decrease in HLA-DR expression is also correlated with the decrease in CD14lowCD16+ inflammatory monocytes (5). Interestingly, COVID-19 patients also exhibit a reduction in HLA-DR that correlates with disease severity and immunosuppression (5).
References
1. Andersson G. (1998). Evolution of the human HLA-DR region. Frontiers in bioscience : a journal and virtual library. https://doi.org/10.2741/a317
2. Shiina, T., Hosomichi, K., Inoko, H., & Kulski, J. K. (2009). The HLA genomic loci map: expression, interaction, diversity and disease. Journal of human genetics. https://doi.org/10.1038/jhg.2008.5
3. Stern, L. J., & Calvo-Calle, J. M. (2009). HLA-DR: molecular insights and vaccine design. Current pharmaceutical design. https://doi.org/10.2174/138161209789105171
4. Zhuang, Y., Peng, H., Chen, Y., Zhou, S., & Chen, Y. (2017). Dynamic monitoring of monocyte HLA-DR expression for the diagnosis, prognosis, and prediction of sepsis. Frontiers in bioscience (Landmark edition). https://doi.org/10.2741/4547
5. Benlyamani, I., Venet, F., Coudereau, R., Gossez, M., & Monneret, G. (2020). Monocyte HLA-DR Measurement by Flow Cytometry in COVID-19 Patients: An Interim Review. Cytometry. Part A : the journal of the International Society for Analytical Cytology. https://doi.org/10.1002/cyto.a.24249
Long Name
Major Histocompatibility Complex Class II DR
Alternate Names
HLA-DRA, HLADR, MHC Class II DR
Gene Symbol
HLA-DRA
Additional HLA-DR Products
Product Documents for HLA-DR Antibody (HLA-DRA/6840R) - Azide and BSA Free
Product Specific Notices for HLA-DR Antibody (HLA-DRA/6840R) - Azide and BSA Free
This product is for research use only and is not approved for use in humans or in clinical diagnosis. Primary Antibodies are guaranteed for 1 year from date of receipt.
Loading...
Loading...
Loading...
Loading...
![Western Blot: HLA-DR Antibody (HLA-DRA/6840R) - Azide and BSA Free [NBP3-20837] - HLA-DR Antibody (HLA-DRA/6840R) - Azide and BSA Free Western Blot: HLA-DR Antibody (HLA-DRA/6840R) - Azide and BSA Free [NBP3-20837] -](https://resources.bio-techne.com/images/products/nbp3-20837_rabbit-hla-dr-mab-hla-dra-6840r-azide-and-bsa-free-2620251694796.jpeg)